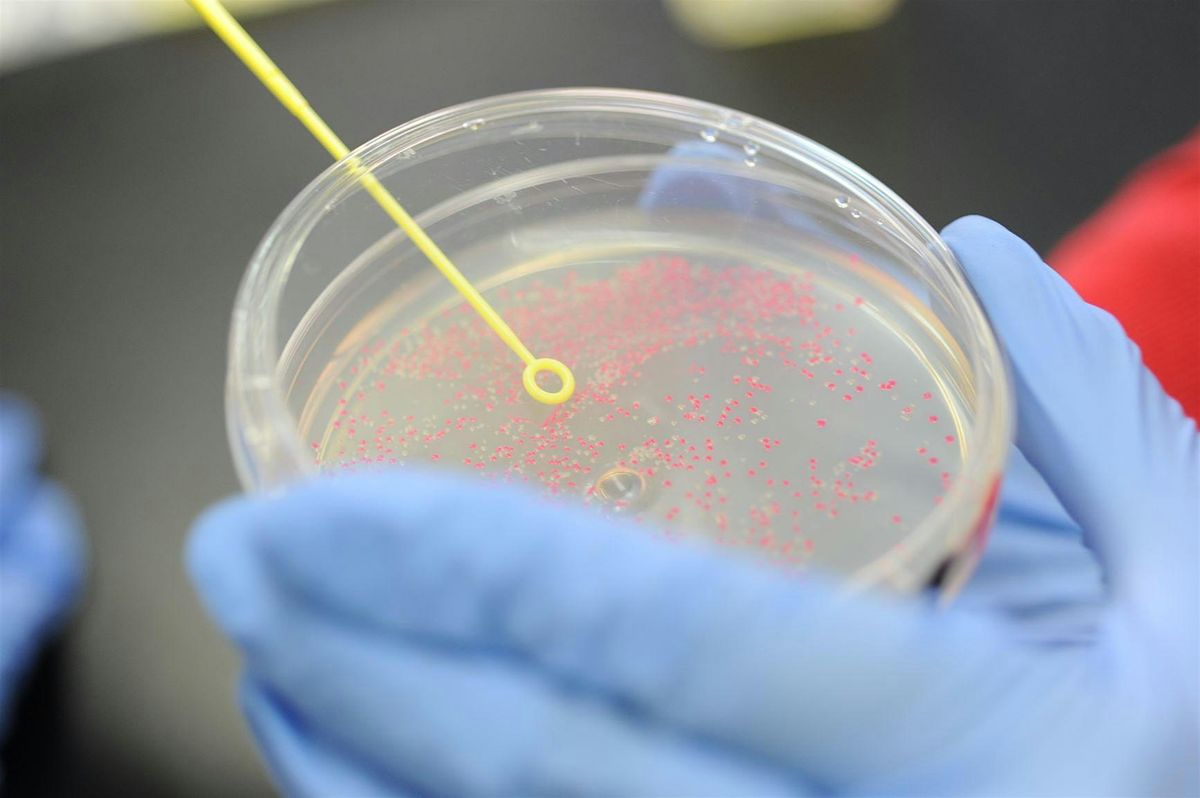

ABE course 2 - Extending DNA manipulation - Hertfordshire 2026
About this Event
Extending practical work - course for teachers and technicians who have attended course 1 previously.
One full day on 25th June (09:30 - 15:30), face to face session with a follow-up 1 hour session online on 26th June (16.00- 17.00) for teachers and technicians who have previously attended our introductory course, Manipulating DNA in the classroom (course 1).
This lab based practical day extends teaching and learning through additional and extension ABE labs; new practical techniques including DNA profiling, transformation and analytical PCR; and new activities and teaching techniques.
Where is it happening?
Event Location & Nearby Stays:
GBP 0.00
















